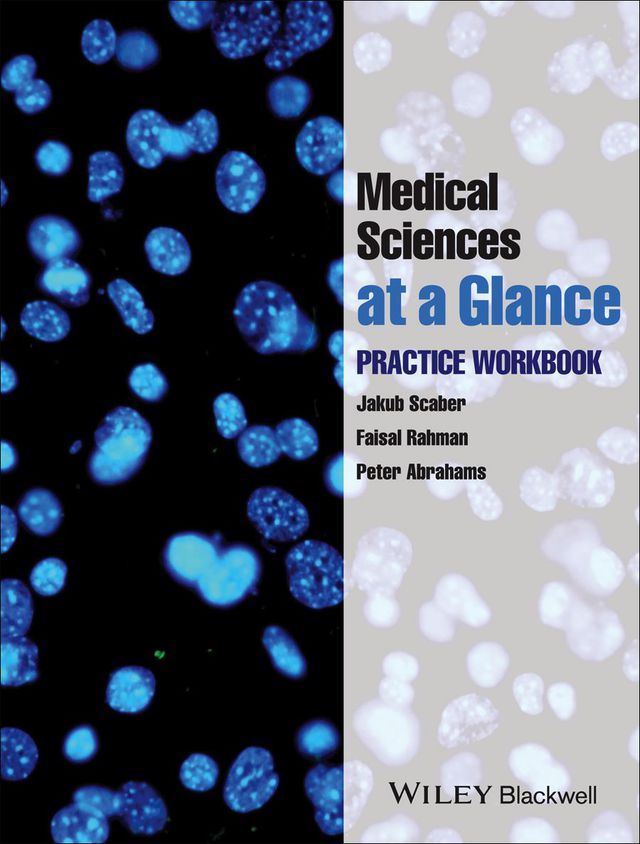
Medical Sciences at a Glance Practice Workbook

-

Fractures of the Facial Skeleton
1ST - 2015ISBN: 9781119064855Regular price R 1,511.00Regular priceUnit price / perWasSale price Now R 1,511.00 -

Washington Manual of Surgical Pathology
2ND - 2012ISBN: 9781469802732Regular price R 1,266.00Regular priceUnit price / perWasSale price Now R 1,266.00 -

Turner and Mcllwraiths Techniques in Large Animal Surgery
4TH - 2013ISBN: 9781118684399Regular price R 2,993.00Regular priceUnit price / perWasSale price Now R 2,993.00 -

Perioperative Practice at a Glance
1ST - 2015ISBN: 9781118842195Regular price R 1,105.00Regular priceUnit price / perWasSale price Now R 1,105.00 -

3D Imaging Technologies in Facial Plastic Surgery an Issue of Facial Plastic Surgery Clinics
1ST - 2012ISBN: 9781455712571Regular price R 2,758.00Regular priceUnit price / perWasSale price Now R 2,758.00 -

Chapman and Nakielnys Guide to Radiological Procedures
7TH - 2017ISBN: 9780702071881Regular price R 1,147.00Regular priceUnit price / perWasSale price Now R 1,147.00 -

Jutas Clinical Guide for Midwives
1ST - 2007ISBN: 9780702197345Regular price R 515.00Regular priceUnit price / perWasSale price Now R 515.00 -

Vascular and Endovascular Surgery at a Glance
1ST - 2014ISBN: 9781118782712Regular price R 1,221.00Regular priceUnit price / perWasSale price Now R 1,221.00 -

Abdominal Ultrasound an Issue of Ultrasound Clinics
1ST - 2019ISBN: 9780323326377Regular price R 2,448.00Regular priceUnit price / perWasSale price Now R 2,448.00 -

Abdominal Wall Reconstruction an Issue of Surgical Clinics
1ST - 2013ISBN: 9780323227438Regular price R 2,448.00Regular priceUnit price / perWasSale price Now R 2,448.00 -

Manual of Perioperative Care an Essential Guide
1ST - 2012ISBN: 9781118302354Regular price R 1,860.00Regular priceUnit price / perWasSale price Now R 1,860.00 -

Patient Care in Radiography
10TH - 2020ISBN: 9780323674355Regular price R 1,981.00Regular priceUnit price / perWasSale price Now R 1,981.00 -

Nurse Educators Guide to Management
4TH - 2021ISBN: 9780627038365Regular price R 733.00Regular priceUnit price / perWasSale price Now R 733.00 -

Anatomic Acl Reconstruction an Issue of Clinics in Sports Medicine
1ST - 2019ISBN: 9781455773589Regular price R 2,448.00Regular priceUnit price / perWasSale price Now R 2,448.00 -

Sexual and Reproductive Health at a Glance
1ST - 2015ISBN: 9781118460757Regular price R 1,157.00Regular priceUnit price / perWasSale price Now R 1,157.00 -

Behavioral Dentistry
2ND - 2013ISBN: 9781118805343Regular price R 1,657.00Regular priceUnit price / perWasSale price Now R 1,657.00 -

International Trauma Life Support for Emergency Care Providers (Pnie)
7TH - 2013ISBN: 9781292034140Regular price R 1,379.00Regular priceUnit price / perWasSale price Now R 1,379.00 -

Evidence-Based Practice Workbook
2ND - 2007ISBN: 9780470766057Regular price R 1,573.00Regular priceUnit price / perWasSale price Now R 1,573.00 -

Oxford Handbook of Anaesthesia
5TH - 2021ISBN: 9780192594662Regular price R 931.00Regular priceUnit price / perWasSale price Now R 931.00 -

Abc of Sports and Exercise Medicine
4TH - 2015ISBN: 9781118887608Regular price R 756.00Regular priceUnit price / perWasSale price Now R 756.00 -

Examination of the Newborn Baby
1ST - 2024ISBN: 9780627041464Regular price R 521.00Regular priceUnit price / perWasSale price Now R 521.00 -

Communicable Disease Control and Health Protection Handbook
4TH - 2018ISBN: 9781119327790Regular price R 2,119.00Regular priceUnit price / perWasSale price Now R 2,119.00 -

Principles of Radiographic Imaging
6TH - 2019ISBN: 9781337673204Regular price R 923.00Regular priceUnit price / perWasSale price Now R 923.00 -

Fundamentals of Research Methodology for Health Care Professionals
5TH - 2022ISBN: 9781485131694Regular price R 368.00Regular priceUnit price / perWasSale price Now R 368.00 -

Step Up to Emergency Medicine
1ST - 2015ISBN: 9781496323668Regular price R 962.00Regular priceUnit price / perWasSale price Now R 962.00 -

Home Community Based Care
1ST - 2008ISBN: 9780627041457Regular price R 606.00Regular priceUnit price / perWasSale price Now R 606.00 -

Nursing 2017 Drug Handbook
37TH - 2016ISBN: 9781496370389Regular price R 891.00Regular priceUnit price / perWasSale price Now R 891.00 -

Rational Emotive Behavioural Counselling in Action
3RD - 2004ISBN: 9781446227077Regular price R 1,035.00Regular priceUnit price / perWasSale price Now R 1,035.00 -
Medical Sciences at a Glance Practice Workbook
1ST - 2013ISBN: 9781118809488Regular price R 814.00Regular priceUnit price / perWasSale price Now R 814.00 -

Cbt With Children Young People and Families
1ST - 2012ISBN: 9781446290491Regular price R 863.00Regular priceUnit price / perWasSale price Now R 863.00 -

Psychiatric Nursing Made Incredibly Easy
2ND - 2014ISBN: 9781496325242Regular price R 868.00Regular priceUnit price / perWasSale price Now R 868.00 -

Articulatory and Phonological Impairments a Clinical Focus
1ST - 2013ISBN: 9781292051840Regular price R 2,014.00Regular priceUnit price / perWasSale price Now R 2,014.00 -

Abc of Transfer and Retrieval Medicine
1ST - 2017ISBN: 9781118719633Regular price R 1,132.00Regular priceUnit price / perWasSale price Now R 1,132.00 -

Therapeutic Nursing Improving Patient Care Through Self Awareness and Reflection
1ST - 2002ISBN: 9781446228401Regular price R 828.00Regular priceUnit price / perWasSale price Now R 828.00 -

Essentials of Acceptance and Commitment Therapy
1ST - 2011ISBN: 9781446242681Regular price R 2,623.00Regular priceUnit price / perWasSale price Now R 2,623.00 -

Gestalt Therapy Therapy of the Situation
1ST - 2012ISBN: 9781446291863Regular price R 932.00Regular priceUnit price / perWasSale price Now R 932.00











